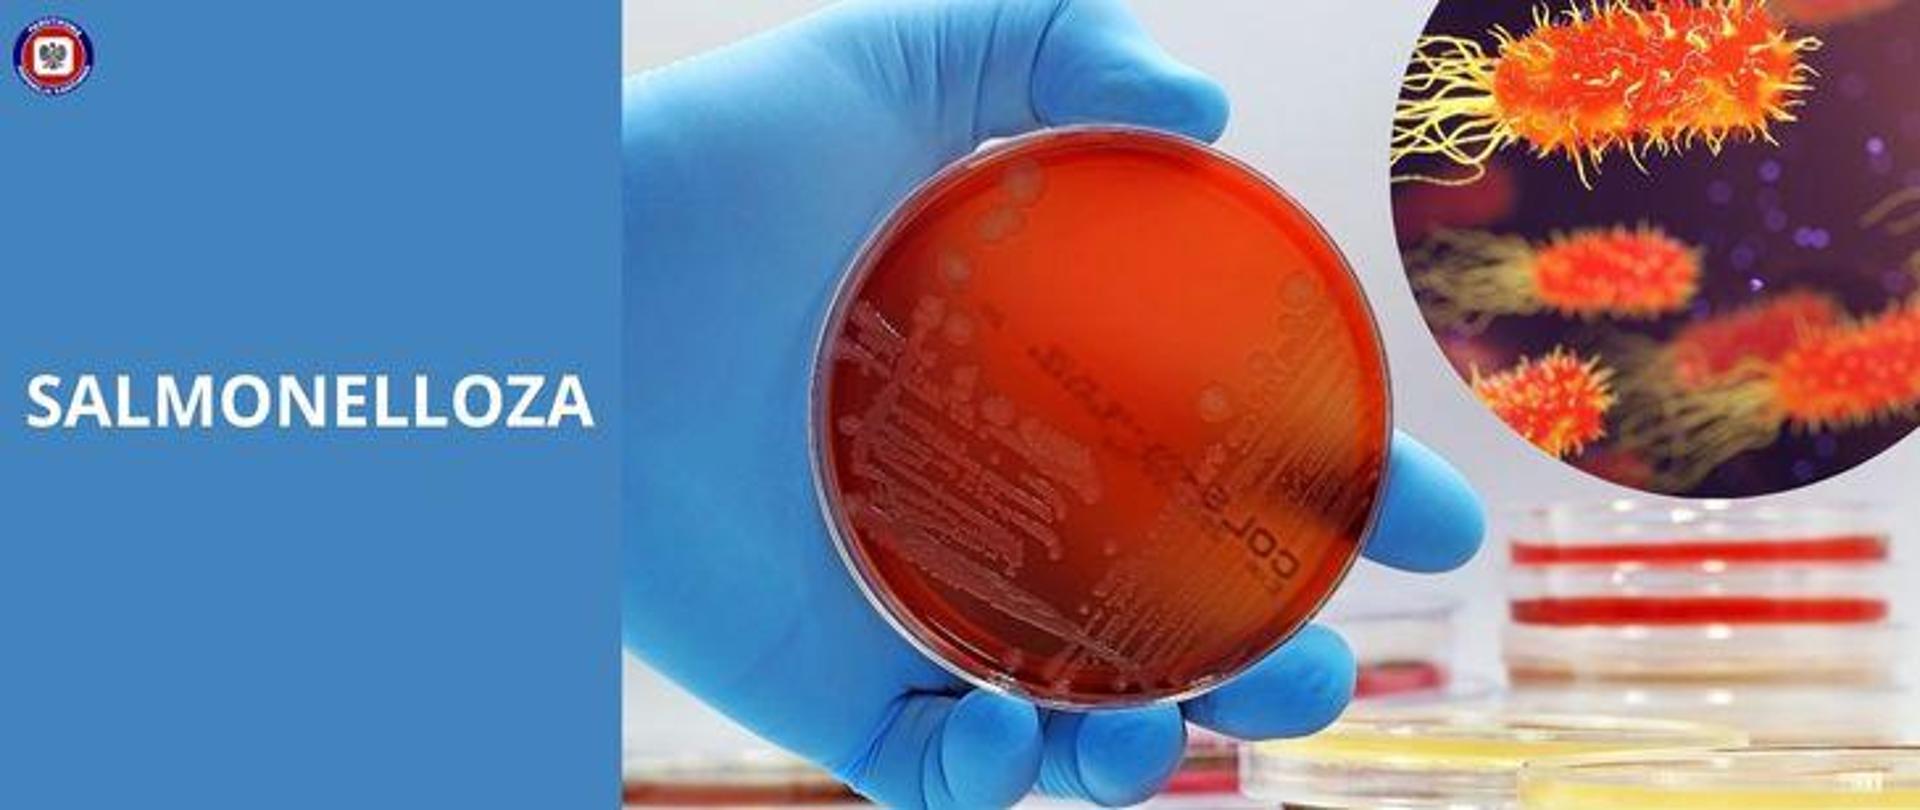
Po prawej w otoczeniu szalek Petriego dłoń w niebieskiej lateksowej rękawiczce trzymająca szalkę Petriego z agarem i wzrostem bakterii. W prawym górnym rogu graficznie przedstawione bakterie Salmonella. Po lewej na niebieskim tle jasny napis "Salmonelloza", w lewym górnym rogu logo Państwowej Inspekcji Sanitarnej.

Salmonelloza
14.08.2024
Salmonelloza to zakaźna choroba pokarmowa wywołana przez bakterie z rodzaju Salmonella, które mogą przedostać się do organizmu człowieka poprzez spożycie skażonej żywności, takiej jak surowe lub niedogotowane mięso, jaja, a także niepasteryzowane produkty mleczne. Bakterie te mogą również znajdować się na powierzchni owoców i warzyw, które nie zostały odpowiednio umyte przed spożyciem, a także kontakt z zakażonymi zwierzętami - szczególnie ptakami, gadami i płazami, oraz z ich odchodami. Choroba może prowadzić do poważnych problemów zdrowotnych, zwłaszcza u osób starszych, dzieci oraz osób z osłabionym układem odpornościowym.
Objawy salmonellozy mogą pojawić się w ciągu 6-48 godzin od zakażenia i obejmują:
- Zaparcia lub biegunkę, która może być wodnista lub zawierać śluz.
- Bóle brzucha i skurcze jelit.
- Nudności i wymioty.
- Gorączkę, zwykle do 39 stopni Celsjusza.
- Osłabienie i bóle głowy i mięśni.
U większości osób objawy utrzymują się od 4 do 7 dni i ustępują samoistnie. W niektórych przypadkach, zwłaszcza u osób z grup ryzyka, choroba może prowadzić do poważniejszych powikłań, takich jak odwodnienie, sepsa czy zakażenie innych narządów.
Podstawowym testem diagnostycznym w kierunku wykrycia infekcji wywołanej przez bakterie z gatunku Salmonella jest badanie kału. Najczęściej wykonywany jest posiew kału, który polega na hodowli i identyfikacji bakterii obecnych w pobranym materiale.
Zapobieganie salmonellozie opiera się głównie na odpowiednich praktykach higienicznych oraz starannym przygotowywaniu posiłków. Oto kluczowe zasady, które warto przestrzegać:
- Dokładne mycie rąk – zawsze myj ręce przed przygotowywaniem posiłków, po kontakcie z surowym mięsem, jajami oraz po skorzystaniu z toalety.
- Staranna obróbka termiczna – gotuj mięso, drób i jaja na odpowiednią temperaturę, aby zabić bakterie Salmonella. Unikaj spożywania surowych jaj oraz potraw zawierających surowe jaja, takich jak tiramisu czy majonez domowej roboty.
- Oddzielanie surowych produktów od gotowych do spożycia – surowe mięso i inne produkty, które mogą być skażone, przechowuj oddzielnie od produktów gotowych do spożycia, aby uniknąć krzyżowego skażenia.
- Mycie owoców i warzyw – dokładnie myj owoce i warzywa przed spożyciem, nawet jeśli zamierzasz je obrać.
- Bezpieczne przechowywanie żywności – przechowuj żywność w odpowiednich warunkach, dbaj o to, aby produkty łatwo psujące się były trzymane w lodówce, a resztki posiłków były przechowywane w szczelnych pojemnikach.
Co zrobić w przypadku podejrzenia zakażenia salmonellozą?
Jeśli podejrzewasz, że mogłeś zarazić się salmonellozą, najważniejsze jest, abyś odpoczywał, pił dużo płynów by uniknąć odwodnienia. Większość przypadków salmonellozy można leczyć w domu, ale jeśli objawy są ciężkie lub utrzymują się dłużej niż tydzień, konieczna może być konsultacja z lekarzem. W przypadku wystąpienia wysokiej gorączki, krwi w stolcu lub silnego odwodnienia, niezwłocznie udaj się do placówki medycznej. W leczeniu salmonellozy, której nie towarzyszą powikłania, nie zaleca się stosowania antybiotyku. Włączenie takiego leczenia może zwiększać ryzyko rozwoju nosicielstwa po ustąpieniu choroby (obecność patogen w przewodzie pokarmowym przy jednoczesnym braku dolegliwości chorobowych).
Salmonelloza jest poważnym zagrożeniem zdrowotnym, które można jednak skutecznie kontrolować, stosując się do podstawowych zasad higieny i bezpiecznego przygotowywania żywności. Pamiętajmy o myciu rąk, odpowiedniej obróbce termicznej produktów oraz właściwym przechowywaniu żywności. Dbając o te aspekty, możemy znacznie zmniejszyć ryzyko zatruć pokarmowych i cieszyć się zdrowiem.